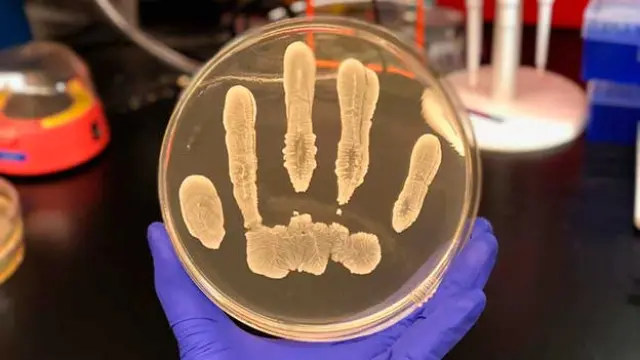

Una bacteria común nos protege contra el cáncer de piel
Muchas de las bacterias presentes en nuestro cuerpo son beneficiosas para la salud. Una nueva investigación que ha llevado a cabo la Universidad de California en San Diego (Estados Unidos) demuestra que los microorganismos buenos de nuestra epidermis nos protegen contra el cáncer de piel, de forma que resulta importante no dañarlos ni destruirlos para permitir que lleven a cabo su acción protectora natural.
La microbiota cutánea es la colección de microorganismos que viven en nuestra piel y suponen la primera línea de defensa contra posibles infecciones y enfermedades. Gracias a ella se previenen problemas como el acné, la psoriasis y otras enfermedades, pero lo que se desconocía hasta el momento es su papel para combatir el cáncer cutáneo.
Este parche de melanina puede prevenir y tratar el cáncer de piel
El equipo descubrió que la cepa de Staphylococcus epidermidis, una bacteria muy común en la piel humana, tiene la capacidad de inhibir el crecimiento de algunos tipos de cáncer. "Esta cepa única de bacterias de la piel produce una sustancia química que mata varios tipos de células cancerosas pero no parece ser tóxica para las células normales", afirma Richard Gallo, director del estudio.
En concreto, esta sustancia se trata de un compuesto químico llamado 6-N-hidroxiaaminopurina (6-HAP). En los ensayos con modelos de ratón, los roedores que no producían el compuesto desarrollaron muchos tumores cutáneos después de exponerse a los rayos ultravioleta (UV) causantes de cáncer, pero los individuos a los que se administró 6-HAP no lo hicieron.
Aprende más sobre el melanoma
El equipo inyectó el compuesto químico protector cada 48 horas durante dos semanas a un grupo de ratones sin que manifestaran efectos secundarios adversos. Cuando trasplantaron células de melanoma, el tamaño del tumor se redujo en más del 50% en comparación con los grupos de control.
Se trata de un estudio temprano y hacen falta más investigaciones para saber si es posible utilizar el 6-HAP para la prevención del cáncer o si la pérdida de esta sustancia aumenta el riesgo de cáncer, pero los resultados preliminares son prometedores.
[Fuente: Universidad de California en San Diego]